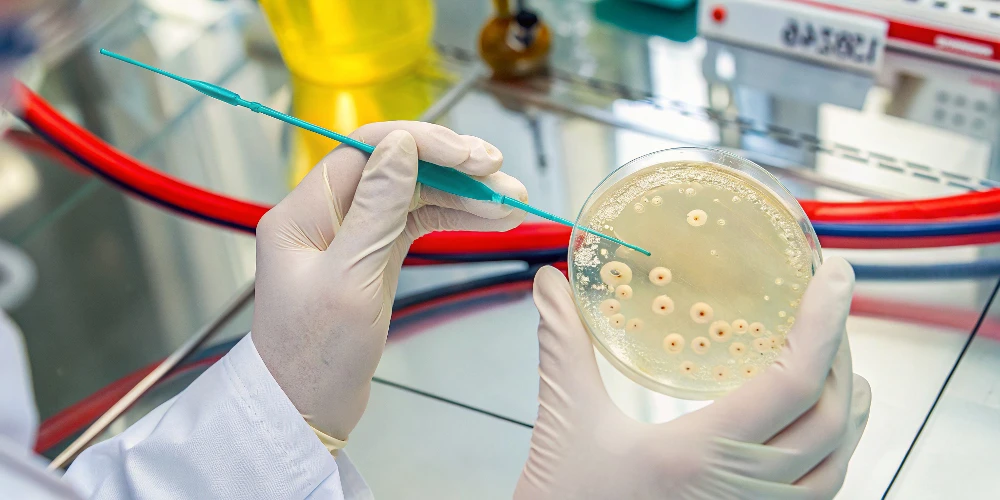
Бактериофаги

56452
56452 56452
56452Открытию бактериофагов, что в переводе с греческого означает «пожиратели бактерий», мир обязан химику Эрнесту Ханкину и Феликсу Д’Эреллю, которые еще в XIX веке, как это часто бывает в науке, каждый по отдельности, открыли новый неопознанный на тот момент биологический объект (как оказалось, вирус), способный поедать бактерии.
В зеркале микроскопа они увидели, как этот объект (бактериофаг) прикреплялся к стенкам бактерий, впрыскивал в них свой генетический материал и начинал размножаться.
Со временем исследователи открыли, что на планете существует огромное количество различных видов бактериофагов, и они играют важную роль в экосистемах, контролируя численность бактерий и участвуя в глобальных биогеохимических циклах. Бактериофаги встречаются как минимум в десять раз чаще, чем бактерии.

Фаги отличаются главным образом по структуре (бывают хвостатые, полиэдрические, плеоморфные, нитевидные), а классифицируют их обычно на основе генетического материала1.
Описаны фазы жизненного цикла фага: литическая (вирулентные фаги), лизогенная, псевдолизогенная (умеренные фаги), хроническая инфицирующая.
Первым шагом в каждом фаговом цикле является связывание фага с рецепторами на поверхности бактерий, после чего фаг вводит свой генетический материал (ДНК или РНК) в клетку2.
Фаги, проходящие литическую фазу, также называемые вирулентными, являются наиболее распространенным типом и наиболее широко используются в терапии бактериофагами из-за их естественной способности убивать бактерии непосредственно путем лизиса клеток.
Фаги, вступающие в фазу лизогенеза, обладают способностью индуцировать трансдукцию, жизненно важный процесс бактериального патогенеза и адаптации. После встречи с таким фагом бактерия переходит в особую форму – профаг, когда фаги интегрируются в геном клетки и вступают с ней в своеобразный симбиоз: бактерия приобретает новые качества и эволюционирует. Именно это свойство бактериофагов привлекло к ним внимание ученых.
Трансдукция используется биологами для переноса генов и устранения устойчивости к антибиотикам или для повышения восприимчивости бактерий к антибиотикам.
Однако работа с фагами не самая простая. Технология очень чувствительная, при неправильных условиях внешней среды фаги теряют свои способности3.
Центральное место в технологии фагового дисплея занимает биология бактериофага, используемого для отображения антител. Для фагового дисплея могут быть использованы различные бактериофаговые системы, в том числе Т4, лямбда, и наиболее популярный нитчатый бактериофаг М134. Фаг М13 не является ни умеренным, ни литическим. Вместо этого он вызывает хроническую инфекцию у своего хозяина, где он постоянно высвобождает новые фаги. Фаг содержит геном одноцепочечной ДНК (оцДНК), состоящий из девяти генов, кодирующих 11 различных белков. Пять из этих белков являются белками оболочки, а остальные шесть белков участвуют в репликации и сборке фага5.
Джордж Смит использовал захватнические возможности фага М13, только перенаправил их на изучение пептидов. Именно фаговый дисплей позволил усовершенствовать пептидные технологии. В 1990-х годах метод фагового дисплея был использован для экспонирования антигенсвязывающих фрагментов иммуноглобулинов на поверхности бактериофага6. В результате появился новый комбинаторный подход к разработке рекомбинантных антител, являющийся альтернативным традиционной гибридомной технологии.
Эксперименты Смита доказали возможность экспрессии чужеродного белка на поверхности бактериофага и их способность специфически связываться с соответствующими антителами. Кроме того, он показал, что используя технологию рекомбинантных ДНК, можно создавать разные популяции бактериофагов, при этом каждый отдельный фаг будет экспонировать на своей поверхности случайные пептиды, что облегчит возможности отбора требуемых вариантов полипептидов и кодирующих их генетических материалов для последующего анализа7.
Изобретение фагового дисплея позволило использовать его как метод изучения иммунного ответа, так и для быстрой селекции и эволюции человеческих антител для последующего использования в терапевтических целях. Библиотеки антител, отображающие на фагах миллионы различных антител, применяет и фарминдустрия для выделения узкоспецифичных терапевтических антител с последующей разработкой лекарств.
Основные направления применения фагового дисплея: изучение пептидов, создание иммуногенов и нановакцин, картирование протеаз и киназ, изучение белков и белковых доменов, отбор антител, изучение белок-лигандных взаимодействий, скрининг экспрессируемых фрагментов кДНК, направленная эволюция белков, изучение механизмов иммунной системы человека.
В 2008 году команда под руководством К. Исии применили фаговый дисплей для характеристики последовательностей, кодирующих иммуноглобулин IgG, у пациента с листовидной пузырчаткой. Оказалось, что два из пяти белков десмоглеинов Dsg1-специфических клонов тяжелой цепи IgG являлись патогенными, вызывая типичное образование пузырей на коже больного8.
В 2012 году Салех и др. клонировали патогенные моноклональные антитела (mAb) против Dsg3 у пациента с паранеопластической пузырчаткой и обнаружили четыре клона, специфичных для Dsg3, три из которых были патогенными9.
Теоретические данные были впоследствии переложены на практику, позволив команде Kouno et al. доставить биологически активные агенты в эпидермис, а именно слитый белок, содержащий непатогенный домен анти-Dsg-scFv10. Этот белок сохранял биологическую активность как в отношении секреции интерферона, так и в отношении апоптоза быстро пролиферирующих лимфоцитов и кератиноцитов.
На мышиной модели он вызывал апоптоз клеток актинического кератоза и ранней плоскоклеточной карциномы.
Исследования позволили предположить, что моноклональные антитела, клонированные от больных пузырчаткой, могут быть использованы в качестве агентов для доставки биологически активных белков в эпидермис для терапии различных иммунологических и неопластических заболеваний11.
Испытывали бактериофагов и для лечения трудно заживающих ран, вызванных Pseudomonas aeruginosa, Staphylococcus aureus и Escherichia coli. Тогда фаза I экспериментов не выявила нежелательных явлений, но и не обнаружила существенной разницы между тестовой и контрольной группами по скорости или частоте заживления12.
В 2019 году американские исследователи применили метод фагового дисплея для изучения Propionibacterium (Cutibacterium) acnes13.
Они использовали фагов как альтернативу традиционной терапии акне антибиотиками, известными резистентностью к P. acnes. Очевидное отсутствие генетического разнообразия бактериофагов P. acnes и их широкий круг хозяев сделали их идеальными кандидатами для фаготерапии акне. Более того, литические бактериофаги, созданные для воздействия на штаммы P. acnes, повышали эффективность терапии.
Маринелли и др. предположили, что фаговые эндолизины могут выступать, например, потенциальным терапевтическим вариантом при лечении акне14. Фаговые эндолизины обладают высокой консервативностью в различных штаммах бактериофагов P. acnes и могут быть активны против большинства штаммов P. acnes. Эндолизины фагов использовались в качестве противомикробных препаратов как in vitro, так и in vivo с многообещающими результатами15.
Была отмечена и способность фагов уменьшать образование биопленок. Многие исследования in vitro и in vivo доказали, что комбинированная терапия антибиотиками и литическими бактериофагами проявляла синергизм, повышая эффективность эрадикации бактерий и биопленок и предотвращая появление резистентных бактерий. Антибиотики также соединялись с бактериофагами для доставки к конкретным бактериям и в более высоких концентрациях16.
Потенциально фаговый дисплей может использоваться при коррекции нежелательных явлений, вызванных применением токсинов. Так, технология фагового дисплея с использованием токсинов разных видов животных (включая токсины змей, скорпионов, пауков и пчел) и использованием библиотек, содержащих мышиные, человеческие и верблюжьи антитела, использовалась для обнаружения фрагментов антител против α-кобратоксина. Этот эксперимент показал, что одноцепочечный вариабельный фрагмент scFv смог защитить от гибели 33 % (2/6) мышей, которым вводили scFv и токсин.
В литературе можно найти несколько примеров селекции фагового дисплея, используемой для обнаружения фрагментов антител, специфичных к токсинам скорпиона и пчелиного токсина. Однако исследования в этой области лишь начинаются17.
Технология фагового дисплея представляет собой надежный, относительно недорогой и простой в реализации подход к поиску антител.
По мере приближения эры устойчивости к антибиотикам исследования новых альтернативных противомикробных агентов приобретают все большую популярность. Бактериофаги здесь обладают рядом преимуществ, которые делают их многообещающей альтернативой традиционной противомикробной терапии.

